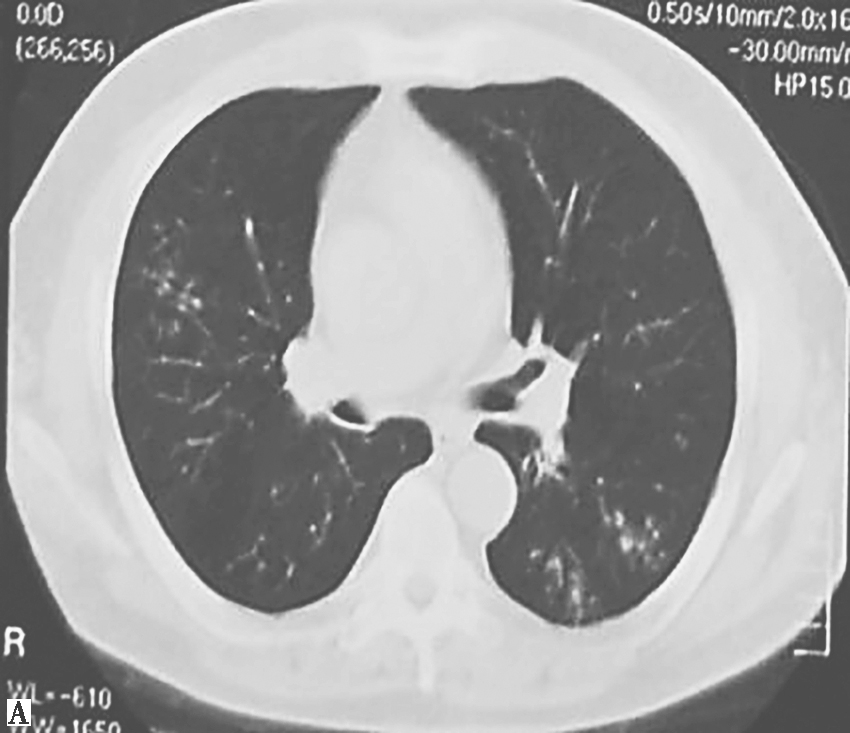
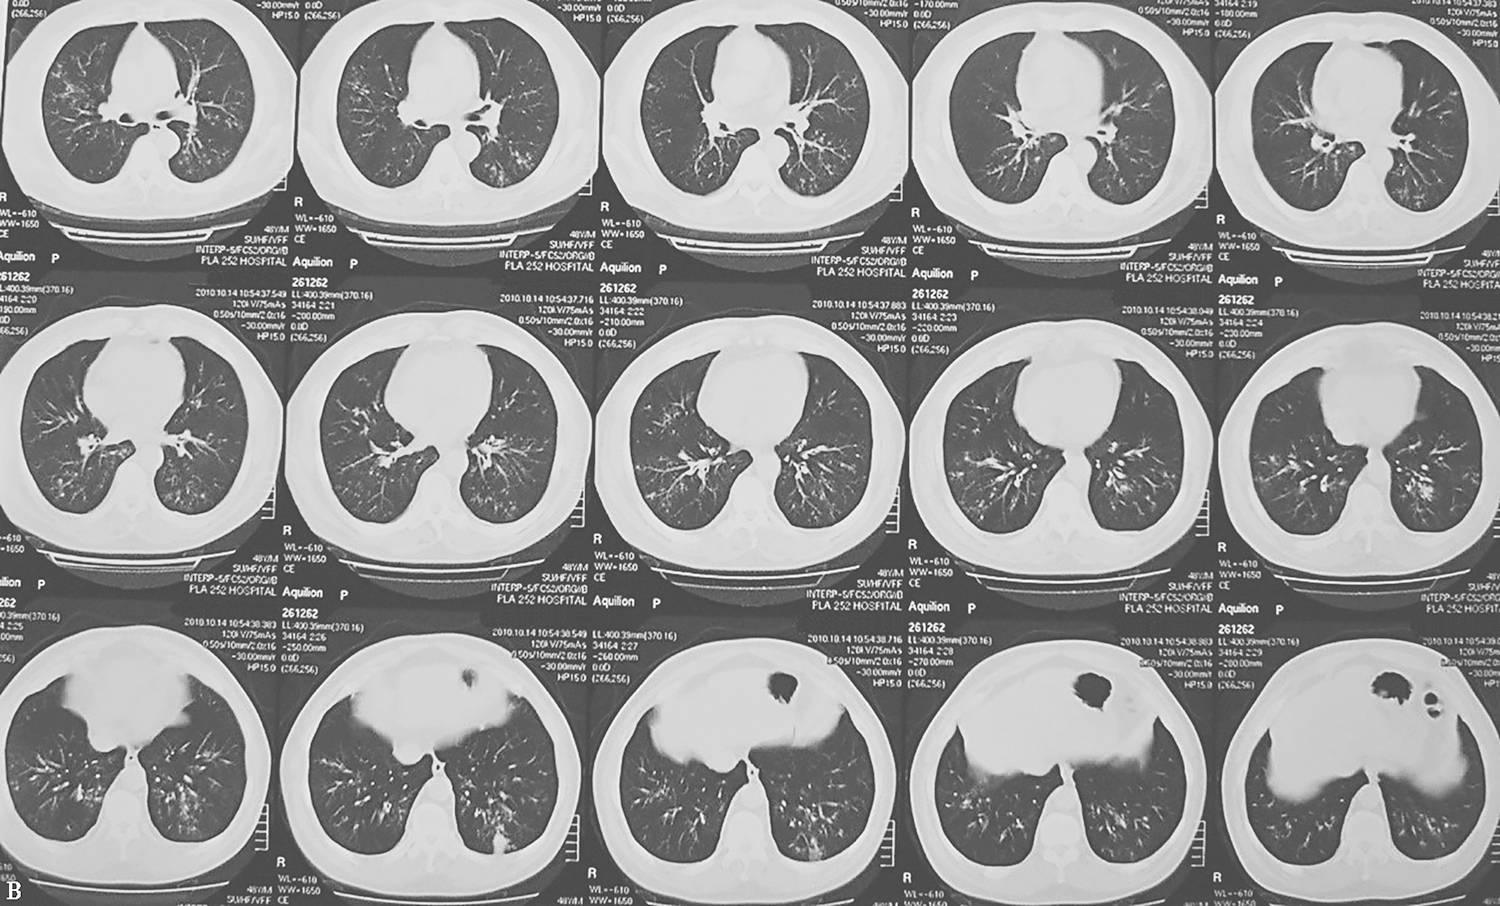

一例重症哮喘合并肌痛、肌无力病例解析
45岁男性,因“发作性喘憋20年,加重3天”被收住急诊科。入院后给予抗炎、平喘、抗感染、呼吸支持等治疗,呼吸系统症状有所减轻而脱机拔管,但出现明显四肢肌力下降。接下来如何诊治?
一、入院疑诊
(一)病例信息
【病史】
男性患者,45岁,因“发作性喘憋20年,加重3天”于2011年12月28日被收住急诊科。患者1991年开始出现反复发作性喘憋,外院诊断为“支气管哮喘”,间断应用沙丁胺醇、地塞米松等,未进行正规诊疗。近3年来,患者几乎每天都有症状,生活处于半自理状态。2011年12月25日,患者出现喘憋明显加重,坐位休息时也有喘息。12月27日,患者至当地医院就诊,经甲泼尼龙(40mg,静脉输注)、茶碱等治疗,效果欠佳,次日病情加重,遂来我院急诊科就医。当时查体:SpO2 79%,心率168次/分,呼吸45次/分,血压150/75mmHg;喘息貌,几乎不能说话,大汗,发绀明显;双肺满布哮鸣音。血气分析(鼻导管,10L/min):pH 7.24,PaCO2 62mmHg,PaO2 102mmHg,
26.6mmol/L。急诊科对患者采取气管插管、机械通气,同时泵入镇静药处理,并收住急诊重症监护室。期间查血常规:WBC 9.67×109/L,N% 63.8%,嗜酸性粒细胞百分比7.4%,嗜酸性粒细胞总数 0.72×109/L,Hb 165g/L,PLT 179×109/L;尿蛋白、红细胞均阴性;肾功能、电解质、肌酸激酶(CK)均正常;总IgE 566U/L,烟曲霉特异性免疫球蛋白G、降钙素原、真菌G试验均阴性;ANCA阴性;痰涂片可见有隔菌丝,分支呈45°,似曲霉菌;痰培养显示有黄曲霉菌及构巢曲霉菌。胸部CT显示双肺多发支气管壁增厚、管腔扩张,多发小叶中心性小结节影。
患者入院后,经镇静(咪达唑仑及阿片受体激动剂)、肌松(维库溴铵)、机械通气、全身性糖皮质激素应用(12月28日开始静脉注射甲泼尼龙40mg,2次/天)及雾化吸入激素(布地奈德)、支气管舒张剂(沙丁胺醇+溴化异丙托品),同时积极补液、纠正电解质及酸碱平衡等综合治疗,仍处于哮喘持续状态,气道峰压持高不降(最高达70cmH2O),遂于12月29日起加用维库溴铵0.8μg/(kg·min)持续泵入,并加大激素量(甲泼尼龙120mg,2次/天),3天后激素渐减量(甲泼尼龙80mg,2次/天×3天至40mg,2次/天×5天)。期间还加用头孢曲松、阿奇霉素抗感染。12月31日痰涂片见有隔菌丝,考虑为曲霉菌感染,遂加用伏立康唑序贯伊曲康唑治疗。患者于2012年1月6日起病情逐渐改善,气道峰压渐降至20~25cmH2O,遂停用维库溴铵,次日拔除气管插管改为间断无创通气支持,并转入呼吸内科病房。
患者平素无反复关节肿痛、口腔溃疡,无明显脱发;无高血压、糖尿病病史;否认传染病病史;不嗜烟酒;家族史无特殊。
【体格检查】
体温36.6℃,血压130/70mmHg,心率122次/分,呼吸18次/分。应答切题,双肺仍可闻明显哮鸣音,心脏未闻病理性杂音,腹部未查及异常,双下肢无水肿,四肢肌力Ⅲ+级,病理征阴性。
(二)临床思辨
【临床特点】
1.患者为中年男性,病程呈慢性,反复出现发作性喘憋。
2.患者在急诊科经积极抗炎、平喘、抗感染、呼吸支持等治疗后,呼吸系统症状有所减轻而脱机拔管,但出现明显四肢肌力下降。
3.发病过程中,患者未出现反复发热、关节肿痛等。
4.胸部CT表现为弥漫性细支气管炎、细支气管扩张(图1)。
5.痰病原学检查提示为曲霉菌感染。

图1 胸部CT表现(2011-12-28)
胸部CT显示双肺多发支气管壁增厚、管腔扩张,多发小叶中心性小结节影
【思辨要点】
1.什么原因造成患者在反复喘息基础上病情明显急性加重?
本例患者长期以来反复发作喘息,外院诊断为“支气管哮喘”,对症予以支气管扩张剂、糖皮质激素后可以缓解,但未规律治疗,结合此次在急诊科就诊时的症状和治疗反应等,考虑可能为“哮喘急性发作、持续状态”。导致患者此次喘息明显加重的原因可能为:
(1)支气管哮喘
本例患者患支气管哮喘多年,未曾规律治疗,每于急性发作时才就诊、治疗。这可能是导致此次哮喘持续状态的主要潜在因素。
(2)以哮喘为表现的系统性疾病
例如,过敏性支气管肺曲霉菌病(ABPA)、系统性血管炎[如嗜酸粒细胞性肉芽肿性多血管炎(eosinophilic granulomatosis with polyangiitis,EGPA)]在临床上都可以表现为难治性哮喘。ABPA是真菌定植后(不局限于曲霉菌)引起的高敏性呼吸系统疾病,临床主要表现为咳嗽、喘息,部分患者有棕色痰栓;外周血嗜酸性粒细胞水平升高、总IgE、特异性IgE水平升高;典型胸部CT表现为肺内游走性阴影,部分病例可以有中心型支气管扩张;一般系统性糖皮质激素疗效良好,但部分患者容易在停用糖皮质激素后发生病情反复。本例患者虽然有呼吸系统存在曲霉菌的证据和弥漫性细支气管扩张表现,但IgE水平和特异性IgE水平都不符合ABPA特点。EGPA是ANCA相关性血管炎的一种,以难治性哮喘为主要临床表现,常伴有周围神经炎(尤其是在病程后期);亦常伴有外周血嗜酸性粒细胞水平明显升高,部分患者可以出现ANCA阳性;胸部CT表现为游走性肺部阴影。本例患者已患病多年,但目前仅有哮喘表现,无其他系统受累,外周血嗜酸性粒细胞水平和ANCA结果、胸部CT表现等也都不支持EGPA诊断。
(3)合并曲霉菌感染
哮喘患者因反复使用系统糖皮质激素或因哮喘未得到良好控制继发支气管扩张等因素,容易合并曲霉菌感染,而曲霉菌感染可能会进一步加重哮喘病情。本例患者曾反复使用糖皮质激素,此次入院期间痰检发现明确曲霉菌感染证据,因此需要高度怀疑该病可能,应在积极控制哮喘的同时,尽快减少系统性糖皮质激素的使用剂量,加强抗真菌治疗,以尽快控制病情发展。
2.本例患者发生重症喘息,行气管插管呼吸机支持后出现肌无力的原因可能有哪些?
(1)镇静剂副作用
本例患者处于哮喘持续状态,为了更好地控制病情,临床采取了肌松、镇静等辅助治疗。肌无力可能是镇静剂等引起的后续效应。这种情况一般在停用上述可疑药物后2~3天得以缓解,而且一般不会造成明显肌肉损伤(如出现肌酶水平明显升高等)。
(2)合并横纹肌溶解
部分重症哮喘患者,因为呼吸肌过度做功以及药物等因素,可出现横纹肌溶解,一般表现为肌无力、血肌酶水平明显升高。
(3)系统性疾病的部分表现
ABPA、EGPA等系统性疾病可导致难治性哮喘,但患者很少会同时出现明显肌无力。
综上所述,对于本例患者,建议继续加强支气管舒张剂和吸入用糖皮质激素治疗,尽快减少直至停用系统性糖皮质激素,同时加强抗真菌治疗,以缓解哮喘症状;同时针对合并的肌无力,应尽快完善血清肌酶谱检查,必要时行肌活检、肌电图等检查来明确病因,并且尽快停用可能影响肌力、造成肌损伤的药物。
二、诊治过程及确诊
(一)临床信息
【辅助检查】
1月8日急查血清CK 2439U/L、Myo 2425μg/L,cTnI、血肌酐正常。
【治疗过程】
结合上述辅助检查结果,考虑患者存在横纹肌溶解综合征,遂予以加强补液、碱化尿液、利尿治疗(病程前期入量和尿量均>4000ml/d,后期维持在2000~4000ml/d),同时逐渐减停静脉激素,加强雾化吸入(布地耐德+复方异丙托溴铵)治疗,并且继续抗曲霉菌治疗,加强补液和功能锻炼。患者血清CK、Myo于1月10日达峰值(分别为3201U/L和3655μg/L),随后逐渐下降;自1月25日起,喘息症状逐渐减轻至缓解;1月28日起,可下地行走,四肢肌力恢复至V-~V级;2月1日起,血清CK和Myo降至正常水平;期间血清肌酐和尿素氮始终保持正常。患者于2月5日出院。
最后诊断:①支气管哮喘;②横纹肌溶解综合征。
(二)临床思辨
横纹肌溶解综合征(rhabdomyolysis syndrome,RMS)是各种原因导致横纹肌损伤后释放大量肌红蛋白等,引起生化指标异常和脏器功能损伤综合征,主要表现为肌痛、肢体无力、茶色尿,常并发电解质紊乱、急性肾衰竭,严重时可危及生命。早期诊断及针对性治疗可改善RMS的预后。若CK升高至正常值5倍以上,在排除心肌损伤引起CK及Myo升高后,可诊断RMS。RMS的病因主要有外伤性和非外伤性两类。其中,非外伤性因素主要包括药物/毒物、感染、代谢紊乱等。引起RMS的常见药物/毒物有降脂药、乙醇(酒精)、毒品、抗精神病药物等,其他如抗组胺药、两性霉素B、抗病毒药物、糖皮质激素(长期大剂量使用)、肌肉松弛药(长时间使用)、β受体激动剂(过多使用)及茶碱(过量)等也有引起RMS的报道。重症哮喘合并RMS的具体发病机制尚不明确,可能为:①肋间内外肌、膈肌、腹肌等强烈收缩导致肌肉损伤;②低氧血症使肌肉缺氧、损伤;③长期大剂量使用糖皮质激素、肌肉松弛药及镇静药物,大量使用β受体激动剂,过量使用茶碱等都可致RMS;④酸中毒可能促进激素受体增加并加重肌溶解等。有研究认为,应用泼尼松>250mg/d×7d或氢化可的松>1000mg/d为RMS易患因素;长期大剂量使用糖皮质激素尤其是与肌肉松弛药联合使用时可引起RMS。至于多大剂量肌肉松弛药、镇静药物、β受体激动剂、茶碱等可以导致RMS,尚无相关报道。
本例患者有多年支气管哮喘史,此次急性加重后采取呼吸机辅助通气并使用大剂量糖皮质激素、支气管舒张剂、多种抗生素(包括抗真菌药物)后,病情逐渐改善而顺利脱机。患者发生RMS可能与如下因素有关:①哮喘持续状态使肌肉强烈收缩及造成肌肉损伤;②患者在入院初甲泼尼龙的平均用量为140mg/d(累积剂量达1680mg),并且间断用维库溴按、镇静药物和茶碱,每天应用β受体激动剂(沙丁胺醇累积量为160mg,日均11.5mg),上述药物协同作用导致的不良反应也可能是发生RMS的原因之一。
精要回顾与启示
对于反复哮喘发作未能良好控制的患者,需要考虑未规律治疗哮喘、以哮喘为表现的系统性疾病或合并曲霉菌感染等因素,进而有针对性地安排鉴别诊断相关检查和治疗。对于重症哮喘患者,在喘息有所控制后,若出现四肢肌力明显下降,除了考虑镇静肌松药物不良反应外,还需要考虑是否合并横纹肌溶解,须及时化验血清肌酶水平等来明确。重症哮喘一旦合并横纹肌溶解,需要及时分析可能的病因,采取针对性处理和加强水化、碱化尿液等措施,以减少肌溶解过程中释放的多种炎性因子、毒素等导致多脏器损伤。
参考文献
[1] LI AM, LI CC, CHIK KW, et al. Rhabdomyolysis following status asthmaticus[J]. Paediatr Child Health, 2001, 37: 409-410.
知识来源
人卫知识数字服务体系
- 评价此内容
- 我要打分
近期推荐
热门关键词
最新会议
- 2013循证医学和实效研究方法学研讨会
- 欧洲心脏病学会年会
- 世界帕金森病和相关疾病2013年会议
- 英国介入放射学学会2013年第25届年会
- 美国血液学会2013年年会
- 美国癫痫学会2013年第67届年会
- 肥胖学会 2013年年会
- 2013年第9届欧洲抗体会议
- 国际精神病学协会 2013年会议
- 妇科肿瘤2013年第18届大会
- 国际创伤压力研究学会2013年第29届…
- 2013年第4届亚太地区骨质疏松症会议
- 皮肤病协会国际2013年会议
- 世界糖尿病2013年大会
- 2013年国际成瘾性药年会
- 彭晓霞---诊断试验的Meta分析
- 武姗姗---累积Meta分析和TSA分析
- 孙凤---Network Meta分析
- 杨智荣---Cochrane综述实战经验分享
- 杨祖耀---疾病频率资料的Meta分析
合作伙伴
Copyright g-medon.com All Rights Reserved 环球医学资讯 未经授权请勿转载!
网络实名:环球医学:京ICP备08004413号-2
关于我们|
我们的服务|版权及责任声明|联系我们
互联网药品信息服务资格证书(京)-经营性-2017-0027
互联网医疗保健信息服务复核同意书 京卫计网审[2015]第0344号




会员登录

